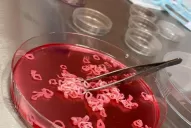
Comida artificial: chefs que cocinan en un laboratorio

La incorporación de la inteligencia artificial, Machine Learning, Big Data y la robótica en la producción alimentaria para responder a las nuevas tendencias en la alimentación y la creciente conciencia sobre el cuidado del medioambiente, durante el proceso de elaboración, es un hecho que se consolida a pasos agigantados en todo el mundo. Y Tucumán no es ajena a esa nueva tendencia.
Las foodtech, empresas que se dedican a proyectos innovadores que tienen como objetivo optimizar la industria de los alimentos a través de la innovación tecnológica, se han convertido en una rama que llama la atención cada vez más a inversores en el mundo de las startup.
La foodtech flexitariana de alimentos congelados Frizata es un empresa emergente pionera en este ámbito. Creada en 2019 es una marca argentina que se consolida en el mercado internacional.
"La idea era crear una marca que desafiara el status quo de cómo se producen los alimentos y la relación con el consumidor final. Existe una tendencia impulsada por las nuevas generaciones que quieren comer saludable y a su vez que la producción de lo que consumen no dañe al medioambiente, es decir, sea sustentable", sostiene a LAGACETA.Com Adolfo Rouillon co-fundador & CEO de Frizata.
Explica además que es una empresa nativa digital, no cuenta con puntos de ventas en las cadenas de supermercados. Actualmente se encuentra presente en Buenos Aires, Córdoba, Rosario, Santiago de Chile, San Pablo y en octubre abrirá su primera tienda virtual en Estados Unidos.

La utilización de la tecnología para brindar un producto integral al consumidor es un aspecto esencial. “Nosotros creamos y co-creamos productos con la información que obtenemos de nuestros clientes mediante el diálogo que establecemos. Al ser una marca digital, no existe en el mundo físico, nos permite generar una conversación en directo con los consumidores, así poder mejorar y crear los alimentos de manera rápida hasta te diría de manera digital ", indica Rouillon.
Alimentos 4.0
La incorporación de la tecnología a la cadena productiva, elaboración, control y distribución, es considera por muchos la cuarta revolución industrial.
"La tecnología 4.0 permite evaluar rápidamente y posteriormente tomar una decisión sobre algún error que este pasando en la producción. Es la nueva fabrica del siglo XXI donde todo esta automatizado", sostiene Karina González docente de la licenciatura en Tecnología y alimentos de la Universidad San Pablo T.
Uno de los aspectos positivos de estas tecnologías es que todos la información y datos que se obtienen no pueden ser manipulados, lo que permite una mayor transparencia en el proceso de elaboración. “La digitalización de la comunicación, los avances con respecto a la robótica y la importancia de la seguridad alimentaria, teniendo en cuenta que muchos de los virus que tenemos surgen de los criaderos de animales; son algunos de los pilares que han llevado al auge de este tema”, añade.
Innovación y conciencia
El 70% de los productos de Frizata no contienen proteína animal un hecho que tiene una repercusión directa en la producción.
"Nosotros tenemos una línea Meet Free (sin carne de animal) que apunta a replicar la textura, experiencia y sabor de la carne sin el uso del animal. En este proceso un equipo de especialista trabaja sobre los puntos mencionados anteriormente para poder llegar al perfil de producto de queremos", destaca Rouillon.

El ceo de Frizata detalla que para lograr estos objetivos se llevan a cabo una serie de procesos en paralelo. "En primer lugar se somete a la proteína vegetal a un proceso de tratamiento térmico para activar enzimas, posteriormente se pasa a un proceso de texturizado y depende del perfil se logra un producto que se parezca más a un grano de carne de vaca o de pescado. Depende del perfil que se busque. Tras este punto, se trabaja en el sabor, el aroma y la mordida".
"Los productos que ofrecemos no contienen conservantes, debido a que el proceso de ultracongelado permite conservar todas las propiedades de los alimentos, lo cuál brinda un producto de alta calidad", cerró.
Producción periodística de Nicolás Córdoba